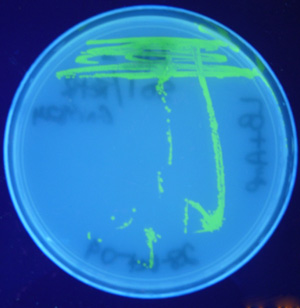
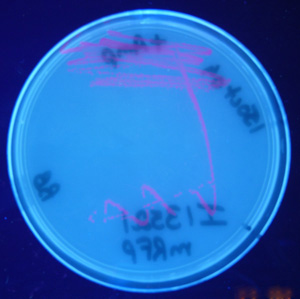

Introductory Synthetic Biology
 |
BIOC 313 |
 |
 |
 |
 |
 |
 |

2008 Rice Synthetic BiOWLogists

We would like to thank New England Biolabs for their generous support of this laboratory course
Copyright, Acknowledgements, and Intended Use
Created by B. Beason (bbeason@rice.edu),
Rice University, 10 July 2006
Updated 13 October 2011
